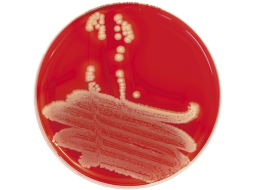
Foto — Zeltainā stafilokoka diagnostika © iStockphoto
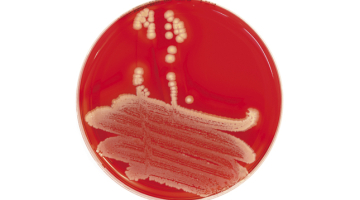
Foto — Zeltainā stafilokoka diagnostika © iStockphoto

rezistents
- Pusdienās
- 20.11.2025.
- Ilze Šķietniece
Laiks potēties!

- Dzīve
- 05.04.2023.
- Agnese Meiere
Karā pret rezistentajām baktērijām

- Analīze
- 16.11.2010.
Baktēriju kaujas
- Pusdienās
- 20.11.2025.
- Ilze Šķietniece
Laiks potēties!
Vakcīna pret gripu vajadzīga ne tikai maziem bērniem, senioriem un hronisku slimību pacientiem, bet ikvienam no mums — lai pasargātu savus tuvos, kam ir vājāka veselība, saka Stradiņa slimnīcas infektoloģe Ieva Voita

- Dzīve
- 05.04.2023.
- Agnese Meiere
Karā pret rezistentajām baktērijām
Latvijas Organiskās sintēzes institūta zinātnieki lielā starptautiskā konsorcijā izstrādājuši jaunu kombinētās terapijas pieeju bakteriālās rezistences apkarošanai. Savukārt citi latviešu zinātnieki rezistences dēļ neizārstējamus pacientus glābj, pateicoties baktēriju vīrusiem jeb bakteriofāgiem

- Analīze
- 16.11.2010.
Baktēriju kaujas
Antibiotikas latvieši lieto prātīgāk nekā daudzviet Eiropā, tomēr ik gadu simtiem dzīvību paņem slimnīcās mītošas baktērijas, kas ir rezistentas pret antibiotikām